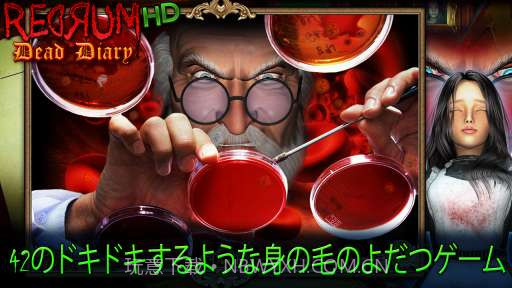
死亡日记 Redrum Dead Diary截图1 死亡日记 Redrum Dead Diary截图1

应用介绍
软件介绍
死亡日记这款游戏让我深陷其中,绝对是个不错的解谜佳作。每个案件都有独特的线索,玩起来像是在跟着小玫一起推理,既刺激又有趣!恐怖元素适度,不会让你太害怕,但又能保持悬疑感,非常适合喜欢思考的人。在上班路上玩几局,轻松解压,还能跟朋友聊剧情,让人倍感愉悦,真的是休闲时光的不二之选。
技术特点
操作手感算是流畅,不过偶尔卡顿
画面风格很有氛围,但细节有点不足
优化不是特别完美,有时候加载慢
编辑点评
编辑点评:死亡日记 Redrum Dead Diary作为休闲益智,相比其他解谜游戏,这里的剧情更吸引人,值得推荐。
适用人群
喜欢推理、解谜的玩家会爱上这款游戏
平时沉迷于恐怖和悬疑题材的人也会觉得有趣
在休闲时间想找点有趣的事情做的人最合适
软件截图
历史版本
v1.11
当前版本
16.4MB
2025-07-12